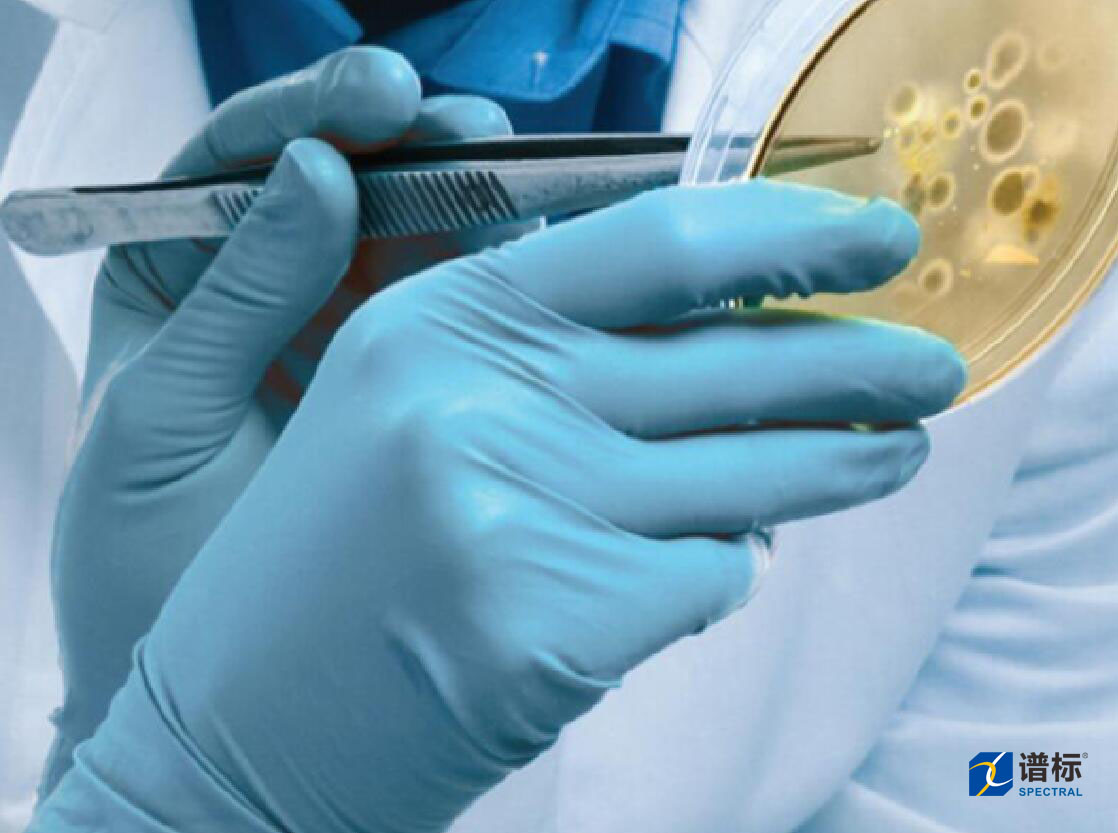

淡水藍譜標一次性無粉丁腈手套

名稱:淡水藍譜標一次性無粉丁腈手套
貨號:NEG38300
類型:檢查手套�����,無粉����,非滅菌
材料:Nitrile Examination 橡膠(NBR)
產(chǎn)地:泰國
顏色:淡水藍
技術(shù)工藝:指尖麻面
針孔率 執(zhí)行標準ISO11193�,GB10123:AQL 1.5 AQL 21.5
扯斷力 執(zhí)行標準ISO37、ISO188 ≥ 7N/6N
存放年限:5年

這是一款集堅韌與舒適于一體的完美型Nitrile Examination一次性丁腈手套��。材料特有的耐化學(xué)腐蝕性���,使其擁有極佳的保護力�����,同時也兼?zhèn)淞己玫目勾檀┬约袄炝?���。采用泰國?yōu)質(zhì)原料,不含可能引起過敏反應(yīng)的乳膠蛋白����,是一款特意為亞洲人設(shè)計的綠色安全手套。藍色的外觀給人以視覺的輕松感�。尤其適用于防護要求高的行業(yè),非防高行業(yè)也可適用���。

產(chǎn)品特點:
出色的耐化學(xué)腐蝕性
加厚設(shè)計創(chuàng)造極佳的防護性
堅韌牢固���,提高安全保護
指尖麻面能更好的抓握
符合人體工學(xué)設(shè)計,適合亞洲人的手型
嚴格按照ISO/GB質(zhì)量標注體系生產(chǎn)
不含天然乳膠成份����,尤為適合I型過敏人群使用
產(chǎn)品通過美國FDA、中國CFDA認證

 400-800-3875
400-800-3875